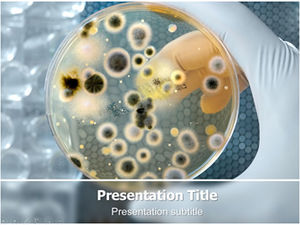
Bakteryjne laboratorium analizy-badania biomedyczne szablon ppt

Twój program jest pobierany
Może to potrwać kilka sekund!
Bezpłatne proste Chemia PowerPoint szablon jest darmowy szablon Chemia do prezentacji PowerPoint, które można pobrać i używać w klasie. Ten darmowy szablon chemii PPT jest dobre dla chemii przedmiotu w szkole, ale także w przypadku projektów dotyczących chemii Uniwersytetu tematu. Możesz pobrać darmowe szablony powerpoint chemii z tej strony internetowej, aby zwiększyć swoje prezentacje PowerPoint.
Ta chemia PPT background for PowerPoint to darmowy PPT kompatybilny z Microsoft Power Point 2007 oraz 2010. Chemii PPT jest bezpłatny i zawiera lekarza z probówki na zielonym tle projektowania i zjeżdżalnia jest dobre dla projektów naukowych i prezentacji PowerPoint oraz chemia chemii internetowym kursy i zajęcia. Szablon ten może być również używany do prezentacji zlewki w laboratorium, a także substancji chemicznych lub kontenera chemii dla cieczy.
Bezpłatne proste Chemia PowerPoint szablon jest darmowy szablon Chemia do prezentacji PowerPoint, które można pobrać i używać w klasie. Ten darmowy szablon chemii PPT jest dobre dla chemii przedmiotu w szkole, ale także w przypadku projektów dotyczących chemii Uniwersytetu tematu. Możesz pobrać darmowe szablony powerpoint chemii z tej strony internetowej, aby zwiększyć swoje prezentacje PowerPoint.
Ta chemia PPT background for PowerPoint to darmowy PPT kompatybilny z Microsoft Power Point 2007 oraz 2010. Chemii PPT jest bezpłatny i zawiera lekarza z probówki na zielonym tle projektowania i zjeżdżalnia jest dobre dla projektów naukowych i prezentacji PowerPoint oraz chemia chemii internetowym kursy i zajęcia. Szablon ten może być również używany do prezentacji zlewki w laboratorium, a także substancji chemicznych lub kontenera chemii dla cieczy.